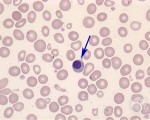

Cabot rings seen in megaloblastic anemia
Cabot rings are ring shape, or figure-8, these inclusions represents nuclear cabot rings can be seen in megaloblastic anemia
cystine crystals in urine sediment
These are cystine crystals.
they are soluble in ammonia
they are soluble in alkaline pH
Crenated cells or Burr Cells
Crenated cell have pucker outer edges. Red cells are covered with 10 – 30 short spicules of regular form. (produced in a blood smear which dries slowly, also can be found in uremia, ...